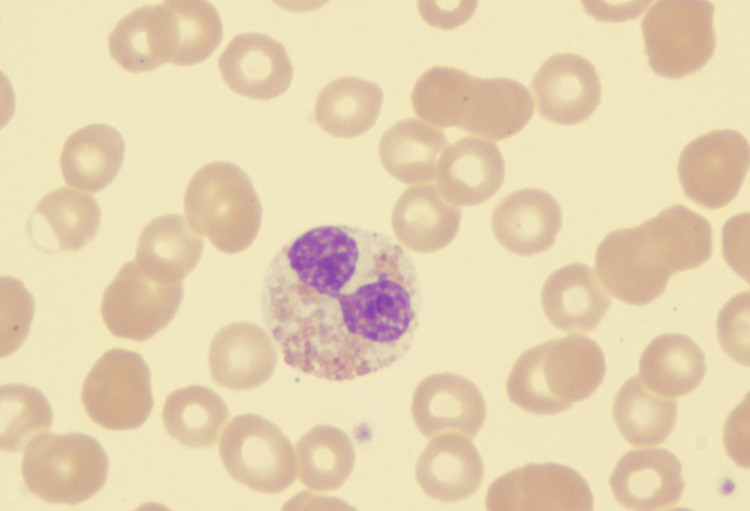
Nieuws van het ASH-congres 2018

Naast BELIEVE is er met MEDALIST nu nog een studie waarin met luspatercept de belangrijkste secundaire evaluatiecriteria bereikt werden versus placebo bij patiënten met een myelodysplastisch syndroom met een zeer laag, laag of middelmatig risico.
Geneesmiddelen die de erytropoëse...
U wenst verder te lezen ?
Toegang tot de volledige artikels is gereserveerd voor professionele zorgverleners.
Indien u een professionele zorgverlener bent, dient u zich aan te melden of u gratis te registreren om volledige toegang te krijgen tot deze inhoud.
Bent u journalist of wenst u ons te informeren, schrijf ons dan op redactie@rmnet.be.